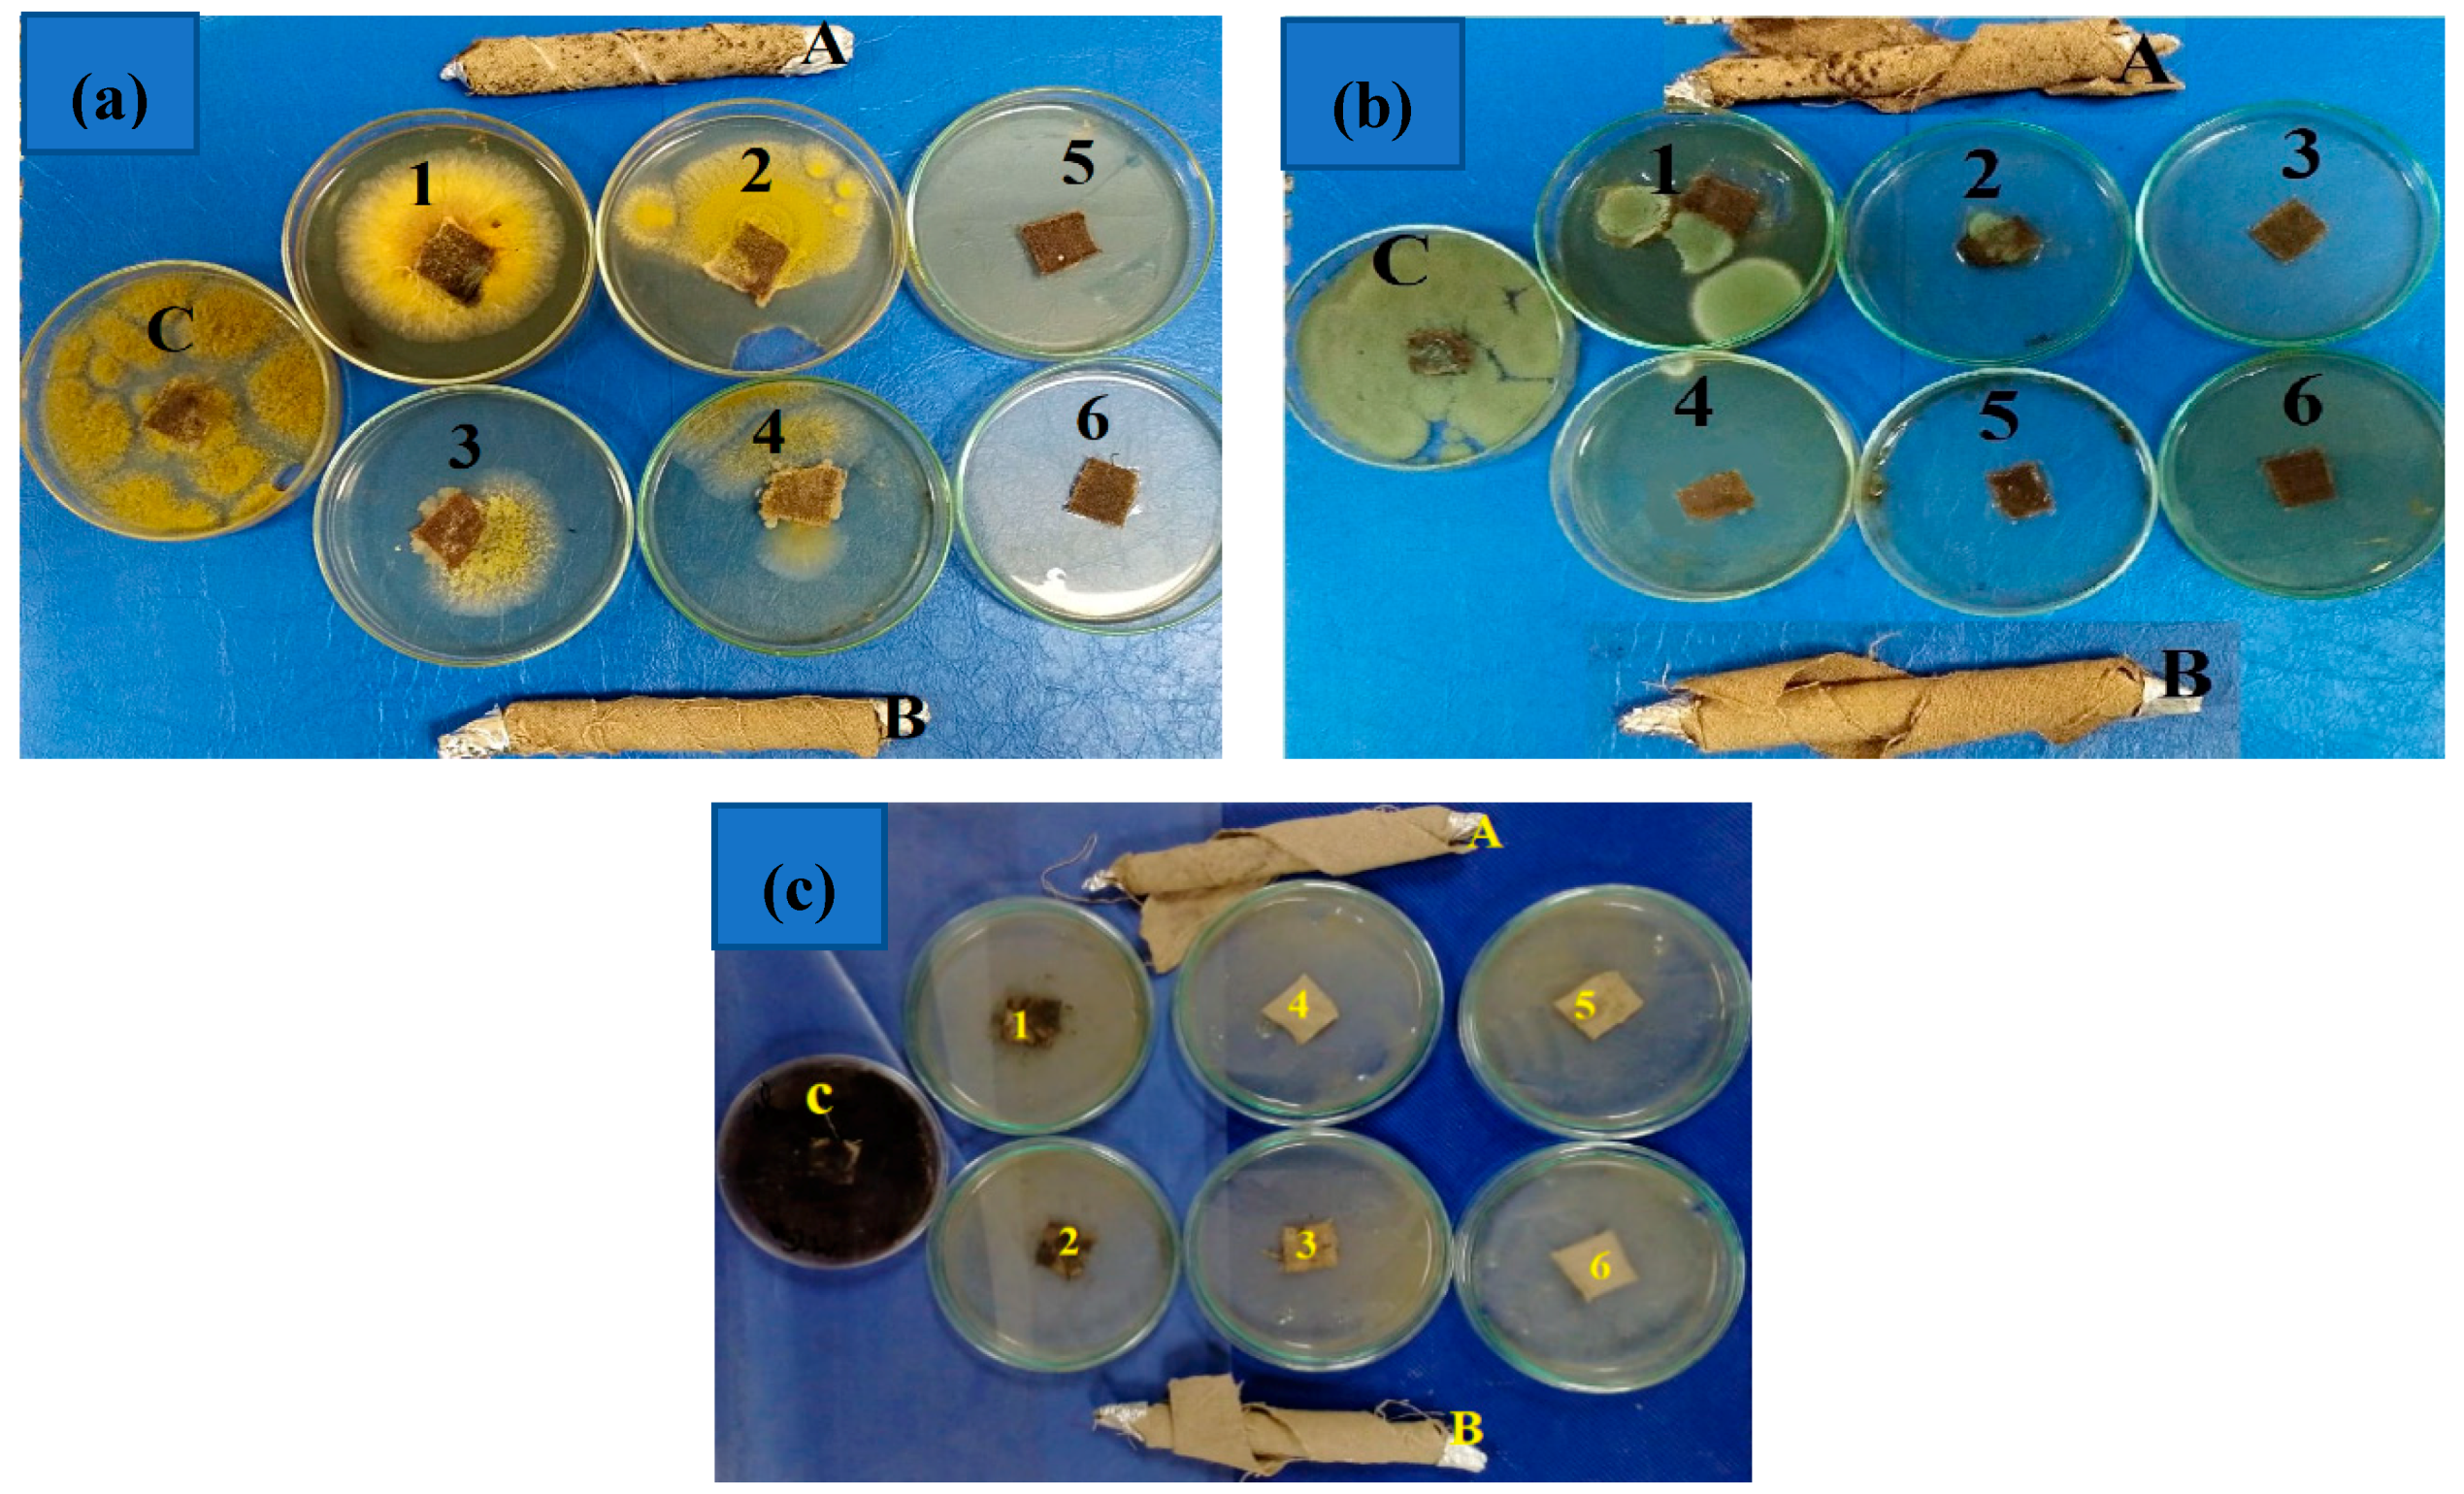

The Biofungicide Activity of Some Plant Essential Oils for the Cleaner Production of Model Linen Fibers Similar to Those Used in Ancient Egyptian Mummification
Abstract
1. Introduction
2. Materials and Methods
2.1. Isolated Fungi from the Ancient Egyptian Child Mummy and Colonization Test
2.2. FTIR Analysis of the Standard, Original, and Infected Linen Samples
2.3. X-ray Diffraction Analysis (XRD) for the Crystallinity Index
2.4. Antifungal Activity of Essential Oils
2.4.1. Plant Material and Essential Oil Extraction
2.4.2. GC/MS Analysis of the EOs
2.4.3. Preparation of Oil Concentrations and Antifungal Activity
2.5. Model Linen of Mummification
2.6. Scanning Electron Microscope (SEM) Examination of Inoculated Linen with Fungi
2.7. Statistical Analysis
3. Results and Discussion
3.1. FTIR Analysis of the Linen
3.2. Cellulose Crystallinity of Linen Fibers
3.3. Antifungal Activity of the EOs
3.4. Chemical Composition of the EOs
3.5. Antifungal Activity of the Model Linen Treated with V. agnus-castus Leaf EO
3.6. SEM Examination
4. Conclusions
Author Contributions
Funding
Acknowledgments
Conflicts of Interest
References
- Salem, M.Z.M.; Zidan, Y.E.; Mansour, M.M.A.; El Hadidi, N.M.N.; Abo Elgat, W.A.A. Antifungal activities of two essential oils used in the treatment of three commercial woods deteriorated by five common mold fungi. Inter. Biodeterior. Biodegrad. 2016, 106, 88–96. [Google Scholar] [CrossRef]
- Ashmawy, N.A.; Al Farraj, D.A.; Salem, M.Z.M.; Elshikh, M.S.; Al-Kufaidy, R.; Alshammari, M.k.; Salem, A.Z.M. Potential impacts of Pinus halepensis Miller trees as a source of phytochemical compounds: Antibacterial activity of the cones essential oil and n-butanol extract. Agrofores. Syst. 2018. [Google Scholar] [CrossRef]
- Al-Huqail, A.A.; Behiry, S.I.; Salem, M.Z.M.; Ali, H.M.; Siddiqui, M.H.; Salem, A.Z.M. Antifungal, antibacterial, and antioxidant activities of Acacia saligna (Labill.) H. L. Wendl. flower extract: HPLC analysis of phenolic and flavonoid compounds. Molecules 2019, 24, 700. [Google Scholar] [CrossRef] [PubMed]
- Behiry, S.I.; Okla, M.K.; Alamri, S.A.; EL-Hefny, M.; Salem, M.Z.M.; Alaraidh, I.A.; Ali, H.M.; Al-Ghtani, S.M.; Monroy, J.C.; Salem, A.Z.M. Antifungal and antibacterial activities of Musa paradisiaca L. peel extract: HPLC analysis of phenolic and flavonoid contents. Processes 2019, 7, 215. [Google Scholar] [CrossRef]
- Behiry, S.I.; EL-Hefny, M.; Salem, M.Z.M. Toxicity effects of Eriocephalus africanus L. leaf essential oil against some molecularly identified phytopathogenic bacterial strains. Nat. Prod. Res. 2019. [Google Scholar] [CrossRef]
- Hamad, Y.K.; Abobakr, Y.; Salem, M.Z.M.; Ali, H.M.; Al-Sarar, A.S.; Al-Zabib, A.A. Activity of plant extracts/essential oils against some plant pathogenic fungi and mosquitoes: GC/MS analysis of bioactive compounds. BioResources 2019, 14, 4489–4511. [Google Scholar] [CrossRef]
- Mohamed, W.A.; Mansour, M.M.A.; Salem, M.Z.M. Lemna gibba and Eichhornia crassipes extracts: Clean alternatives for deacidification, antioxidation and fungicidal treatment of historical paper. J. Clean. Prod. 2019, 219, 846–855. [Google Scholar] [CrossRef]
- Okla, M.K.; Alamri, S.A.; Salem, M.Z.M.; Ali, H.M.; Behiry, S.I.; Nasser, R.A.; Alaraidh, I.A.; Al-Ghtani, S.M.; Soufan, W. Yield, phytochemical constituents, and antibacterial activity of essential oils from the leaves/twigs, branches, branch wood, and branch bark of Sour Orange (Citrus aurantium L.). Processes 2019, 7, 363. [Google Scholar] [CrossRef]
- Salem, M.Z.M.; Behiry, S.I.; EL-Hefny, M. Inhibition of Fusarium culmorum, Penicillium chrysogenum and Rhizoctonia solani by n-hexane extracts of three plant species as a wood-treated oil fungicide. J. Appl. Microbiol. 2019, 126, 1683–1699. [Google Scholar] [CrossRef]
- Taha, A.S.; Salem, M.Z.M.; Abo Elgat, W.A.A.; Ali, H.M.; Hatamleh, A.A.; Abdel-Salam, E.M. Assessment of the impact of different treatments on technological and antifungal properties of produced Papyrus (Cyperus papyrus L.) sheets. Materials 2019, 12, 620. [Google Scholar] [CrossRef]
- Taha, A.S.; Abo Elgat, W.A.A.; Salem, M.Z.M.; Ali, H.M.; Fares, Y.G.E.; Elshikh, M.S. Impact of some plant source additives on enhancing the properties and antifungal activities of pulp made from Linen fibers. BioResources 2019, 14, 6025–6046. [Google Scholar]
- Tajidin, N.E.; Ahmad, S.H.; Rosenani, A.B.; Azimah, H.; Munirah, M. Chemical composition and citral content in lemongrass (Cymbopogon citratus) essential oil at three maturity stages. Afri. J. Biotechnol. 2012, 11, 2685–2693. [Google Scholar] [CrossRef]
- Pengelly, A. The Constituents of Medicinal Plants (Eds): An Introduction to the Chemistry and Therapeutics of Herbal Medicine; CABI Publishing: England, UK, 2004; pp. 85–103. [Google Scholar]
- de Silva, B.C.; Guterres, S.S.; Weisheimer, V.; Schapoval, E.E.S. Antifungal activity of the lemongrass oil and citral against Candida species. Braz. J. Infect. Dis. 2008, 12, 63–66. [Google Scholar] [CrossRef] [PubMed]
- Schaneberg, B.T.; Khan, I.A. Comparison of extraction methods for marker compounds in the essential oil of lemongrass by GC. J. Agric. Food Chem. 2002, 50, 1345–1349. [Google Scholar] [CrossRef]
- Daferera, D.J.; Ziogas, B.N.; Polissiou, M.G. The effectiveness of plant essential oils on the growth of Botrytis cinerea, Fusarium sp. and Clavibacter michiganensis sub sp. michiganensis. Crop. Prot. 2003, 22, 39–44. [Google Scholar] [CrossRef]
- Naik, M.I.; Fomda, B.A.; Jaykumar, E.; Bhat, J.A. Antibacterial activity of lemongrass (Cymbopogon citratus) oil against some selected pathogenic bacteria. Asian Pac. J. Trop. Med. 2010, 3, 535–538. [Google Scholar] [CrossRef]
- Domokos, J.; Hethelyi, E.; Palinkas, J.; Szirmai, S.; Tulok, M.H. Essential oil of rosemary (Rosmarinus officinalis L.) of Hungarian origin. J. Essent. Oil Res. 1997, 9, 41–45. [Google Scholar] [CrossRef]
- Salido, S.; Altarejos, J.; Nogueras, M.; Sanchez, A.; Lugue, P. Chemical composition and seasonal variations of rosemary oil from southern Spain. J. Essen. Oil Res. 2003, 15, 10–14. [Google Scholar] [CrossRef]
- Hendel, N.; Larous, L.; Belbey, L. Antioxidant activity of rosemary (Rosmarinus officinalis L.) and its in vitro inhibitory effect on Penicillium digitatum. Int. Food Res. J. 2016, 23, 1725–1732. [Google Scholar]
- Stojković, D.; Soković, M.; Glamočlija, J.; Džamić, A.; Ćirić, A.; Ristić, M.; Grubišić, D. Chemical composition and antimicrobial activity of Vitex agnus-castus L. fruits and leaves essential oils. Food Chem. 2011, 128, 1017–1022. [Google Scholar] [CrossRef]
- Merle, H.; Verdeguer, M.; Blazquez, M.A.; Boira, H. Chemical composition of the essential oils from Eriocephalus africanus L. var. africanus populations growing in Spain. Flavour Fragr. J. 2007, 22, 461–464. [Google Scholar] [CrossRef]
- Salie, F.; Eagles, P.F.; Leng, H.M. Preliminary antimicrobial screening of four South African Asteraceae species. J. Ethnopharmacol. 1996, 52, 27–33. [Google Scholar] [CrossRef]
- Górny, R.L.; Reponen, T.; Willeke, K.; Schmechel, D.; Robine, E.; Boissier, M.; Grinshpun, S.A. Fungal fragments as indoor air biocontaminants. Appl. Environ. Microbiol. 2002, 68, 3522–3531. [Google Scholar] [CrossRef] [PubMed]
- Piñar, G.; Piombino-Mascali, D.; Maixner, F.; Zink, A.; Sterflinger, K. Microbial survey of the mummies from the Capuchin Catacombs of Palermo, Italy: Biodeterioration risk and contamination of the indoor air. FEMS Microbiol. Ecol. 2013, 86, 341–356. [Google Scholar] [CrossRef] [PubMed]
- Geweely, N.S.; Afifi, H.A.; Ibrahim, D.M.; Soliman, M.M. Efficacy of essential oils on fungi isolated from archaeological objects in Saqqara excavation, Egypt. Geomicrobiol. J. 2019, 36, 148–168. [Google Scholar] [CrossRef]
- Allsopp, D.E. Worldwide wastage: The economics of biodeterioration. Microbiol. Tod. 2011, 38, 150–153. [Google Scholar]
- Kavkler, K.; Gunde-Cimerman, N.; Zalar, P.; Demsar, A. Fungal contamination of textile objects preserved in Slovene museums and religious institutions. Int. Biodeterior. Biodegrad. 2015, 97, 51–59. [Google Scholar] [CrossRef]
- Sterflinger, K. Fungi: Their role in deterioration of cultural heritage. Fungal Biol. Rev. 2010, 24, 47–55. [Google Scholar] [CrossRef]
- Montegut, D.; Indictor, N.; Koestler, R. Fungal deterioration of cellulosic textiles: A review. Int. Biodeterior. 1991, 28, 209–226. [Google Scholar] [CrossRef]
- Sequeira, S.; Cabrita, E.J.; Macedo, M.F. Antifungals on paper conservation: An overview. Int. Biodeterior. Biodegrad. 2012, 74, 67–86. [Google Scholar] [CrossRef]
- Gutarowska, B.; Pietrzak, K.; Machnowski, W.; Milczarek, J.M. Historical textiles – a review of microbial deterioration analysis and disinfection methods. Tex. Res. J. 2017, 87, 2388–2406. [Google Scholar] [CrossRef]
- Montanari, M.; Melloni, V.; Pinzari, F.; Innocenti, G. Fungal biodeterioration of historical library materials stored in Compactus movable shelves. November 2012. Int. Biodeterior. Biodegrad. 2012, 75, 83–88. [Google Scholar] [CrossRef]
- Lech, T.; Ziembinska-Buczynska, A.; Krupa, N. Analysis of microflora present on historical textiles with the use of molecular techniques. Int. J. Conserv. Sci. 2015, 6, 137–144. [Google Scholar]
- Čavka, M.; Glasnović, A.; Janković, I.; Sikanjić, P.; Perić, B.; Brkljacić, B.; Mlinarić-Missoni, E.; Skrlin, J. Microbiological analysis of a mummy from the archeological museum in Zagreb. Coll. Antropol. 2010, 34, 803–805. [Google Scholar] [PubMed]
- Mansour, M. Impact of storage conditions on biodeterioration of ancient Egyptian child mummies by xerophilic fungi. Egy. J. Archaeol. Restorat. Stud. 2018, 8, 97–107. [Google Scholar]
- Miller, A.; Laiz, L.; Dionísio, A.; Macedo, M.; Saiz-Jimenez, C. Growth of phototrophic biofilms from limestone monuments under laboratory conditions. Int. Biodeterior. Biodegr. 2009, 63, 860–867. [Google Scholar] [CrossRef]
- Segal, L.; Creely, J.J.; Martin, A.E., Jr.; Conrad, C.M. An empirical method for estimating the degree of crystallinity of native cellulose using the X-ray diffraction. Tex. Res. J. 1959, 29, 786–794. [Google Scholar] [CrossRef]
- Salem, M.Z.M.; Ali, H.M.; El-Shanhorey, N.A.; Abdel-Megeed, A. Evaluation of extracts and essential oil from Callistemon viminalis leaves: Antibacterial and antioxidant activities, total phenolic and flavonoid contents. Asian Pac. J. Trop. Med. 2013, 6, 785–791. [Google Scholar] [CrossRef]
- Hussein, H.S.; Salem, M.Z.M.; Soliman, A.M. Repellent, attractive, and insecticidal effects of essential oils from Schinus terebinthifolius fruits and Corymbia citriodora leaves on two whitefly species, Bemisia tabaci and Trialeurodes ricini. Sci. Hortic. 2017, 216, 111–119. [Google Scholar] [CrossRef]
- Wiley/NIST. The Wiley/NBS Registry of Mass Spectral Data, 8th ed.; Wiley: New York, NY, USA, 2008. [Google Scholar]
- Salem, M.Z.M.; Mansour, M.M.A.; Elansary, H.O. Evaluation of the effect of inner and outer bark extracts of Sugar Maple (Acer saccharum var. saccharum) in combination with citric acid against the growth of three common molds. J. Wood Chem. Technol. 2019, 39, 136–147. [Google Scholar] [CrossRef]
- EL-Hefny, M.; Ashmawy, N.A.; Salem, M.Z.M.; Salem, A.Z.M. Antibacterial activity of the phytochemicals-characterized extracts of Callistemon viminalis, Eucalyptus camaldulensis and Conyza dioscoridis against the growth of some phytopathogenic bacteria. Microb. Pathog. 2017, 113, 348–356. [Google Scholar] [CrossRef] [PubMed]
- Salem, M.Z.M.; Zidan, Y.E.; Mansour, M.M.A.; El Hadidi, N.M.N.; Abo Elgat, W.A.A. Evaluation of usage three natural extracts applied to three commercial wood species against five common molds. Inter. Biodeterior. Biodegrad. 2016, 110, 206–226. [Google Scholar] [CrossRef]
- Salem, M.Z.M.; Mansour, M.M.A.; Mohamed, W.S.; Ali, H.M.; Hatamleh, A.A. Evaluation of the antifungal activity of treated Acacia saligna wood with Paraloid B-72/TiO2 nanocomposites against the growth of Alternaria tenuissima, Trichoderma harzianum, and Fusarium culmorum. Bio. Res. 2017, 12, 7615–7627. [Google Scholar]
- Lopez, P.; Sanchez, C.; Batlle, R.; Nerin, C. Solid-and vapor-phase antimicrobial activities of six essential oils: Susceptibility of selected foodborne bacterial and fungal strains. J. Agric. Food Chem. 2005, 53, 6939–6946. [Google Scholar] [CrossRef]
- Nedorostova, L.; Kloucek, P.; Kokoska, L.; Stolcova, M.; Pulkrabek, J. Antimicrobial proprieties of selected essential oils in vapour phase against foodborne bacteria. Food Control. 2009, 20, 157–160. [Google Scholar] [CrossRef]
- Zimmermann, B.; Tkalčec, Z.; Mešić, A.; Kohler, A. Characterizing aeroallergens by Infrared Spectroscopy of fungal spores and pollen. PLoS ONE 2015, 10, e0124240. [Google Scholar] [CrossRef]
- Gerd, W.; Margarete, P.; Dietrich, F. Hexafluoropropanol as Valuable Solvent for Lignin in UV and IR Spectroscopy. Holzforschung 1983, 37, 303–307. [Google Scholar]
- Kosa, G.; Kohler, A.; Tafintseva, V.; Zimmermann, B.; Forfang, K.; Afseth, N.K.; Tzimorotas, D.; Vuoristo, K.S.; Horn, S.J.; Mounier, J.; et al. Microtiter plate cultivation of oleaginous fungi and monitoring of lipogenesis by high-throughput FTIR spectroscopy. Microb. Cell Fact. 2017, 16, 101. [Google Scholar] [CrossRef]
- Zhang, Y.L.; Chen, J.; Lei, Y.; Zhou, Q.; Sun, S.; Noda, I. Discrimination of different red wine by Fourier transform infrared and two-dimensional infrared correlation spectroscopy. J. Mol. Struct. 2010, 974, 144–150. [Google Scholar] [CrossRef]
- Herrera, R.; Erdocia, X.; Llano-Ponte, R.; Labidi, J. Characterization of hydrothermally treated wood in relation to changes on its chemical composition and physical properties. J. Anal. Appl. Pyrol. 2014, 107, 256–266. [Google Scholar] [CrossRef]
- Zhou, C.; Jiang, W.; Cheng, Q.; Via, B.K. Multivariate calibration and model integrity for wood chemistry using Fourier transform infrared spectroscopy. J. Anal. Methods Chem. 2015, 1–9. [Google Scholar] [CrossRef] [PubMed]
- Gandolfo, D.S.; Mortimer, H.; Woodhall, J.W.; Boonham, N. Fourier transform infra-red spectroscopy using an attenuated total reflection probe to distinguish between Japanese larch, pine and citrus plants in healthy and diseased states. Spectrochim Acta A 2016, 163, 181–188. [Google Scholar] [CrossRef] [PubMed]
- Salem, M.Z.M.; Hamed, S.A.M.; Mansour, M.M.A. Assessment of efficacy and effectiveness of some extracted bio-chemicals as bio-fungicides on Wood. Drv. Ind. 2019, 70, 337–350. [Google Scholar] [CrossRef]
- Hong, Y.; Dashtban, M.; Chen, S.; Song, R.; Qin, W. Lignin in paper mill sludge is degraded by white-rot fungi in submerged fermentation. J. Microb. Biochem. Technol. 2015, 7, 177–181. [Google Scholar]
- Shi, J.; Xing, D.; Lia, J. FTIR Studies of the Changes in Wood Chemistry from Wood Forming Tissue under Inclined Treatment. Energy Procedia 2012, 16, 758–762. [Google Scholar] [CrossRef]
- Mohebby, B. Attenuated total reflection infrared spectroscopy of white-rot decayed beech wood. Int. Biodeterior. Biodegrad. 2005, 55, 247–251. [Google Scholar] [CrossRef]
- Silva-Carvalho, R.; Silva, J.P.; Ferreirinha, P.; Leitão, A.F.; Andrade, F.K.; Gil da Costa, R.M.; Cristelo, C.; Rosa, M.F.; Vilanova, M.; Gama, F.M. Inhalation of Bacterial Cellulose Nanofibrils Triggers an Inflammatory Response and Changes Lung Tissue Morphology of Mice. Toxicol. Res. 2019, 35, 45–63. [Google Scholar] [CrossRef]
- Duarte, E.B.; das Chagas, B.S.; Andrade, F.K.; Brígida, A.I.S.; Borges, M.F.; Muniz, C.R.; Souza Filho, M.D.S.M.; Morais, J.P.S.; Feitosa, J.P.A.; Rosa, M.F. Production of hydroxyapatite-bacterial cellulose nanocomposites from agroindustrial wastes. Cellulose 2015, 22, 3177–3187. [Google Scholar] [CrossRef]
- Warnock, M.; Davis, K.; Wolf, D.; Gbur, E. Soil Burial Effects on Biodegradation and Properties of Three Cellulosic Fabrics; University of Arkansas: Fayetteville, AR, USA, 2011. [Google Scholar]
- Hussain, A.I.; Anwar, F.; Chatha, S.A.S.; Jabbar, A.; Mahboob, S.; Nigam, P.S. Rosmarinus officinalis essential oil: Antiproliferative, antioxidant and antibacterial activities. Braz. J. Microbiol. 2010, 41, 1070–1078. [Google Scholar] [CrossRef]
- Takayama, C.; Meirade-Faria, F.; Almeida, A.C.A.; Dunder, R.J.; Manzo, L.P.; Socca, E.A.R.; Batista, L.M.; Salvador, M.J.; Souza-Brito, A.R.M.; Luiz-Ferreira, A. Chemical composition of Rosmarinus officinalis essential oil and antioxidant action against gastric damage induced by absolute ethanol in the rat. Asian Pac. J. Trop. Biomed. 2016, 6, 677–681. [Google Scholar] [CrossRef]
- Zaouali, Y.; Bouzaine, T.; Boussaid, M. Essential oils composition in two Rosmarinus officinalis L. varieties and incidence for antimicrobial and antioxidant activities. Food Chem Toxicol. 2010, 48, 3144–3152. [Google Scholar] [CrossRef] [PubMed]
- Zoghbi, M.G.B.; Andrade, E.H.; Maia, J.G.S. The essential oil of Vitex agnus-castus L. growing in the Amazon region. Flav. Frag. J. 1999, 14, 211–213. [Google Scholar] [CrossRef]
- Asdadi, A.; Hamdouch, A.; Oukacha, A.; Moutaj, R.; Gharby, S.; Harhar, H.; El Hadek, M.; Chebli, B.; Idrissi-Hassani, L.M. Study on chemical analysis, antioxidant and in vitro antifungal activities of essential oil from wild Vitex agnus-castus L. seeds growing in area of Argan tree of Morocco against clinical strains of Candida responsible for nosocomial infections. J. Mycol. Med. 2015, 25, e118–e127. [Google Scholar] [PubMed]
- Gonçalves, R.; Vanessa, F.; Ayres, S.; Carlos, E.; Carvalho, M.G.M.; Souza, A.C.; Guimarães, G.M.; Corrêa, C.H.G.; Martins, R.T.; Eliane, O.S.; et al. Chemical composition and antibacterial activity of the essential oil of Vitex agnus-castus L. (Lamiaceae). An. Da Acad. Bras. De Ciências 2017, 89, 2825–2832. [Google Scholar]
- Yilar, M.; Bayan, Y.; Onaran, A. Chemical composition and antifungal effects of Vitex agnus-castus L. and Myrtus communis L. Plants. Not. Bot. Horti. Agrobo. 2016, 44, 466–471. [Google Scholar] [CrossRef]
- Badawy, M.E.I.; Abdelgaleil, S.A.M. Composition and antimicrobial activity of essential oils isolated from Egyptian plants against plant pathogenic bacteria and fungi. Ind Crop. Prod. 2014, 52, 776–782. [Google Scholar] [CrossRef]
- Hassan, R.R.A.; Mansour, M.M.A. A microscopic study of paper decayed by Trichoderma harzianum and Paecilomyces variotii. J. Polym. Environ. 2018, 26, 2698–2707. [Google Scholar] [CrossRef]

| Oil | Concentration µL/mL | Inhibition of Fungal Mycelial (%) | ||
|---|---|---|---|---|
| A. flavus | C. cladosporioides | P. chrysogenum | ||
| E. africanus leaves | 0 (control) | 0.00 | 0.00 | 0.00 |
| 125 | 0.00 | 7.04 ± 0.64 | 18.14 ± 0.64 | |
| 250 | 37.41 ± 0.64 | 62.59 ± 0.64 | 46.29 ± 0.64 | |
| 500 | 61.85 ± 0.64 | 65.18 ± 0.64 | 58.52 ± 0.64 | |
| 750 | 68.88 ± 1.11 | 100 ± 0.00 | 75.92 ± 1.69 | |
| 1000 | 80.37 ± 0.64 | 100 ± 0.00 | 80.74 ± 0.64 | |
| 2000 | 87.77 ± 1.11 | 100 ± 0.00 | 100 ± 0.00 | |
| V. agnus-castus leaves | 0 (control) | 0.00 | 0.00 | 0.00 |
| 125 | 76.29 ± 0.64 | 40 ± 1.11 | 51.85 ± 0.64 | |
| 250 | 100 ± 0.00 | 71.48 ± 0.64 | 100 ± 0.00 | |
| 500 | 100 ± 0.00 | 100 ± 0.00 | 100 ± 0.00 | |
| 750 | 100 ± 0.00 | 100 ± 0.00 | 100 ± 0.00 | |
| 1000 | 100 ± 0.00 | 100 ± 0.00 | 100 ± 0.00 | |
| 2000 | 100 ± 0.00 | 100 ± 0.00 | 1000.00 | |
| C. citratus leaves | 0 (control) | 0.00 | 0.00 | 0.00 |
| 125 | 8.15 ± 0.64 | 9.63 ± 6.41 | 2.59 ± 0.64 | |
| 250 | 49.26 ± 0.64 | 74.07 ± 0.64 | 19.63 ± 0.64 | |
| 500 | 100 ± 0.00 | 100 ± 0.00 | 54.81 ± 0.64 | |
| 750 | 100 ± 0.00 | 100 ± 0.00 | 100 ± 0.00 | |
| 1000 | 100 ± 0.00 | 100 ± 0.00 | 100 ± 0.00 | |
| 2000 | 100 ± 0.00 | 100 ± 0.00 | 100 ± 0.00 | |
| R. officinalis leaves | 0 (control) | 0.00 | 0.00 | 0.00 |
| 125 | 3.71 ± 0.64 | 8.88 ± 1.11 | 5.18 ± 7.14 | |
| 250 | 42.59 ± 1.69 | 15.92 ± 6.41 | 18.14 ± 6.41 | |
| 500 | 58.88 ± 1.11 | 18.88 ± 1.11 | 51.48 ± 0.64 | |
| 750 | 74.44 ± 1.11 | 20.74 ± 6.41 | 69.63 ± 6.41 | |
| 1000 | 88.51 ± 0.64 | 41.48 ± 0.64 | 88.51 ± 0.64 | |
| 2000 | 100 ± 0.00 | 100 ± 0.00 | 100 ± 0.00 | |
| V. agnus-cactus fruits | 0 (control) | 0.00 | 0.00 | 0.00 |
| 125 | 6.66 ± 1.11 | 13.33 ± 11.11 | 0.37 ± 0.64 | |
| 250 | 48.52 ± 0.64 | 18.52 ± 0.64 | 16.29 ± 0.64 | |
| 500 | 63.71 ± 0.64 | 67.77 ± 1.11 | 47.41 ± 0.64 | |
| 750 | 76.66 ± 1.11 | 100 ± 0.00 | 70.37 ± 0.64 | |
| 1000 | 80.74 ± 0.64 | 100 ± 0.00 | 88.15 ± 1.28 | |
| 2000 | 100 ± 0.00 | 100 ± 0.00 | 100 ± 0.00 | |
| p-value | <0.0001 | <0.0001 | <0.0001 | |
| Compound Name | R.T. (min) | Area % | Molecular Formula | Molecular Weight | Standard Index | Reverse Standard Index |
|---|---|---|---|---|---|---|
| β-Myrcene | 8.36 | 12.37 | C10H16 | 136 | 955 | 951 |
| β-Citral | 18.4 | 43.63 | C10H16O | 152 | 934 | 934 |
| geranial (e-citral) | 19.41 | 41.51 | C10H16O | 152 | 926 | 926 |
| 9-octadecenoic acid | 31.08 | 0.92 | C18H34O2 | 282 | 832 | 795 |
| 1,3-Diolein | 32.82 | 1.57 | C39H72O5 | 620 | 794 | 758 |
| Compound Name | R.T. (min) | Area % | Molecular Formula | Molecular Weight | Standard Index | Reverse Standard Index |
|---|---|---|---|---|---|---|
| α-Pinene | 6.99 | 20.41 | C10H16 | 136 | 957 | 956 |
| Camphene | 7.7 | 2.59 | C10H16 | 136 | 961 | 938 |
| Limonene | 10.09 | 2.72 | C10H16 | 136 | 928 | 924 |
| Eucalyptol | 10.46 | 30.75 | C10H18O | 154 | 950 | 947 |
| Linalool | 12.86 | 2.74 | C10H18O | 154 | 951 | 938 |
| Camphor | 15.9 | 18.15 | C10H16O | 152 | 954 | 952 |
| Borneol | 16.17 | 5.94 | C10H18O | 154 | 911 | 907 |
| Verbenone (2-Pinen-4-one) | 18.41 | 2.29 | C10H14O | 150 | 929 | 916 |
| Ethyl iso-allocholate | 32.53 | 6.77 | C26H44O5 | 436 | 822 | 801 |
| Compound Name | R.T. (min) | Area % | Molecular Formula | Molecular Weight | Standard Index | Reverse Standard Index |
|---|---|---|---|---|---|---|
| α-Thujene | 6.7 | 0.21 | C10H16 | 136 | 948 | 912 |
| α-Pinene | 7 | 0.47 | C10H16 | 136 | 958 | 950 |
| Sabinene (β-Thujene) | 8.39 | 12.2 | C10H16 | 136 | 970 | 962 |
| β-Pinene | 8.63 | 0.56 | C10H17 | 136 | 949 | 946 |
| 1-Octen-3-ol | 9.2 | 0.69 | C8H16O | 128 | 945 | 931 |
| Terpinolene | 9.72 | 0.22 | C10H16 | 136 | 932 | 881 |
| Eucalyptol | 10.68 | 20.59 | C10H18O | 154 | 950 | 950 |
| γ-Terpinene | 11.19 | 0.46 | C10H16 | 136 | 136 | 896 |
| Linalool | 12.88 | 0.34 | C10H18O | 154 | 946 | 932 |
| Terpinen-4-ol | 16.11 | 2 | C10H18O | 154 | 930 | 930 |
| α-Terpineol | 16.84 | 1.67 | C10H18O | 154 | 941 | 938 |
| Linalyl acetate | 17.24 | 0.31 | C12H20O2 | 196 | 896 | 889 |
| (−)-α-Gurjunene | 21.61 | 0.62 | C15H24 | 204 | 930 | 915 |
| Caryophyllene | 22.42 | 23.13 | C15H24 | 204 | 960 | 960 |
| β-Farnesene | 22.73 | 6.14 | C15H24 | 204 | 943 | 941 |
| (+)-Aromadendrene | 23.66 | 3.26 | C15H24 | 204 | 930 | 913 |
| γ-Elemene | 24.91 | 9 | C15H25 | 204 | 927 | 900 |
| Viridiflorol | 27.02 | 0.33 | C15H26O | 222 | 872 | 812 |
| (−)-Spathulenol | 27.58 | 1.79 | C15H24O | 220 | 922 | 891 |
| Caryophyllene oxide | 27.65 | 4.06 | C15H24O | 220 | 901 | 869 |
| Ledol | 27.88 | 0.97 | C15H26O | 222 | 876 | 846 |
| β-Cadin-4-en-10-ol | 28.53 | 1.19 | C15H26O | 222 | 843 | 793 |
| (Z)-9-octadecenoic acid | 30.01 | 0.55 | C18H34O2 | 282 | 777 | 763 |
| Arachidonic acid methyl ester | 30.94 | 1.98 | C21H34O2 | 318 | 844 | 786 |
| 2-Methylenecholestan-3-ol | 31.68 | 3.35 | C28H48O | 400 | 818 | 765 |
| 1-Heptatriacotanol | 32.11 | 2.77 | C37H76O | 536 | 826 | 805 |
| Compound Name | R.T.(min) | Area % | Molecular Formula | Molecular Weight | Standard Index | Reverse Standard Index |
|---|---|---|---|---|---|---|
| α-Pinene | 6.18 | 2.58 | C10H16 | 136 | 911 | 913 |
| β-Thujene | 7.43 | 1.32 | C10H16 | 136 | 899 | 901 |
| Eucalyptol | 9.51 | 16.65 | C10H18O | 154 | 928 | 930 |
| cis-Caryophyllene | 20.26 | 3.73 | C15H24 | 204 | 906 | 907 |
| γ-Elemene | 22.74 | 41.59 | C15H24 | 204 | 876 | 880 |
| Caryophyllene oxide | 25.09 | 2.55 | C15H24O | 220 | 773 | 787 |
| Preg-4-en-3-one,17α-hydroxy-17β-cyano- | 27.74 | 0.82 | C20H27NO2 | 313 | 744 | 750 |
| Geranyllinalool | 29.79 | 17.98 | C20H34O | 290 | 831 | 835 |
| (Nerolidyl acetate) | 30.36 | 11.63 | C17H28O2 | 264 | 742 | 743 |
| Nerolidol | 31.53 | 1.16 | C15H26O | 222 | 784 | 813 |
| Oil Concentration (µL/mL) | Growth Inhibition (%) | ||
|---|---|---|---|
| A. flavus | C. cladosporioides | P. chrysogenum | |
| 0 (control) | 0.00 e | 0.00 d | 0.00 d |
| 125 | 9.25 ± 3.2 d | 75.92 ± 3.21 c | 29.63 ± 3.2 c |
| 250 | 38.88 ± 5.55 c | 78.14 ± 0.64 b | 92.59 ± 3.21 b |
| 500 | 72.22 ± 5.55 b | 100 a | 100 a |
| 750 | 75.92 ± 3.21 b | 100 a | 100 a |
| 1000 | 100 a | 100 a | 100 a |
| 2000 | 100 a | 100 a | 100 a |
© 2020 by the authors. Licensee MDPI, Basel, Switzerland. This article is an open access article distributed under the terms and conditions of the Creative Commons Attribution (CC BY) license (http://creativecommons.org/licenses/by/4.0/).
Share and Cite
Mansour, M.M.A.; EL-Hefny, M.; Salem, M.Z.M.; Ali, H.M. The Biofungicide Activity of Some Plant Essential Oils for the Cleaner Production of Model Linen Fibers Similar to Those Used in Ancient Egyptian Mummification. Processes 2020, 8, 79. https://doi.org/10.3390/pr8010079
Mansour MMA, EL-Hefny M, Salem MZM, Ali HM. The Biofungicide Activity of Some Plant Essential Oils for the Cleaner Production of Model Linen Fibers Similar to Those Used in Ancient Egyptian Mummification. Processes. 2020; 8(1):79. https://doi.org/10.3390/pr8010079
Chicago/Turabian StyleMansour, Maisa M. A., Mervat EL-Hefny, Mohamed Z. M. Salem, and Hayssam M. Ali. 2020. "The Biofungicide Activity of Some Plant Essential Oils for the Cleaner Production of Model Linen Fibers Similar to Those Used in Ancient Egyptian Mummification" Processes 8, no. 1: 79. https://doi.org/10.3390/pr8010079
APA StyleMansour, M. M. A., EL-Hefny, M., Salem, M. Z. M., & Ali, H. M. (2020). The Biofungicide Activity of Some Plant Essential Oils for the Cleaner Production of Model Linen Fibers Similar to Those Used in Ancient Egyptian Mummification. Processes, 8(1), 79. https://doi.org/10.3390/pr8010079

